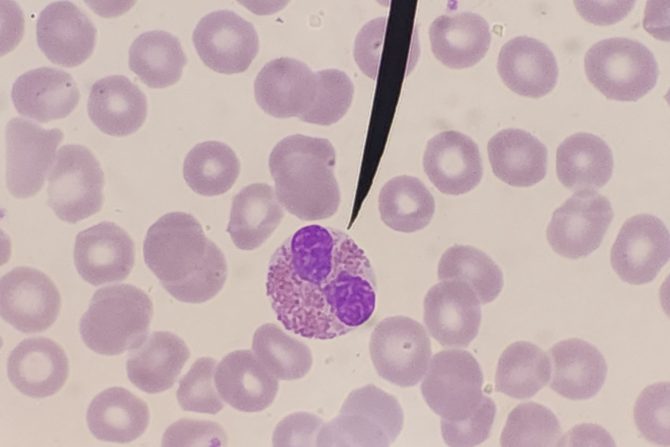
povišen nivo granulocita

Šta znači kada je povišen nivo granulocita u analizi krvi
Test krvi je jedini način da se proveri nivo granulocita, a granulocitoza ili povišen nivo granulocita u krvi ima mnogo uzroka i nisu svi ozbiljni
Povišen nivo granulocita u krvi poznat je pod nazivom granulocitoza i javlja se kao odgovor na infekcije, autoimune bolesti, ali na rak ćelija krvi. Granulociti su kategorija belih krvnih zrnaca koje cirkulišu u krvi (neutrofili, eozinofili, bazofili) ili ostaju u tkivu (mastociti). Oni rade zajedno u borbi protiv infekcija, alergena i uzroka upale u telu. Sadrže enzimske granule koje se formiraju u citoplazmi (gust, polutečan rastvor koji ispunjava svaku ćeliju). Kada upala/infekcija dospe u naše telo, granulociti "žure" u to područje i oslobađaju svoje granule kako bi se borili protiv infekcije.
Povišen nivo granulocita najčešće ukazuje na infekciju
Test krvi je jedini način da se proveri nivo granulocita. Povišen nivo granulocita u krvi može da znači da čovek ima neku vrstu infekcije. Nenormalno visok broj belih krvnih zrnaca obično ukazuje na bolest ili infekciju. S druge strane, nizak broj granulocita može da ukaže na poremećaje koštane srži poput leukemije ili aplastične anemije. Drugi nazivi za granulocite su granularni leukociti, polimorfonuklearni leukociti ili PMN ćelije.
Granulocitoza se može da se javi i u slučajevima bakterijske infekcije krvotoka, sepse, opekotina, usled ekstremnog izlaganja stresu, zapaljenja creva, reumatoidnog artritisa, insuficijencije bubrega, srčanog udara, metastatskog raka, upotrebe određenih lekova...
Granulocitoza ima mnogo uzroka i nisu svi ozbiljni
Iako su granulociti normalan deo našeg imunog sistema, previše granulocita u krvi obično znači da postoji zdravstveni problem, poput infekcije. Druga stanja, koja su u tesnoj vezi sa granulocitozom su autoimune bolesti kao što je reumatoidni artritis i bolesti koštane srži poput hronične mijeloidne leukemije (CML). Koliko god da je uznemirujuće saznanje da imate abnormalno visoke nivoe najzastupljenije vrste belih krvnih zrnaca u telu - pokušajte da ne brinete. Granulocitoza ima mnogo uzroka i nisu svi ozbiljni.
eKlinika zadržava sva prava nad sadržajem. Za preuzimanje sadržaja pogledajte uputstva na stranici Uslovi korišćenja.


